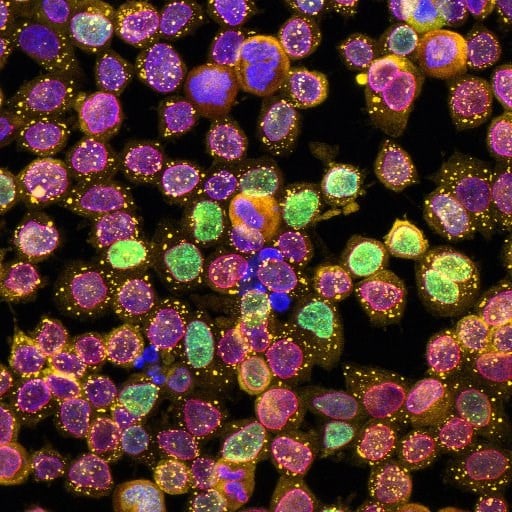

Molecular Medicine

The Molecular Medicine program at SickKids develops molecular approaches for the prevention, diagnosis, and treatment of human diseases by understanding and identifying molecular structures and mechanisms.
Internationally recognized as one of the leading centres for structural biology worldwide, we combine biophysical, computational, chemical, biochemical, microbiological, and cell biological tools to study the molecular foundations of normal and pathological processes. Program investigators continuously push the frontiers of technology and multidisciplinary approaches in advancing research, supported by SickKids’ world-class labs and infrastructure.
We are hiring! Applications open for Program Head, Molecular Medicine
The Research Institute at The Hospital for Sick Children (SickKids) is seeking a dynamic research leader and outstanding scientist to be Head of the Molecular Medicine Program. Research in this program aims to understand fundamental molecular mechanisms that underpin biological responses, in part to guide development of molecular approaches for prevention, diagnosis, and treatment of disease. Program faculty apply advanced biophysical, chemical, biochemical, microbiological, cell biological, computational and structural biology approaches across different model systems.
The search will prioritize candidates whose expertise covers one or more of the following areas: (i) machine learning-based design of protein, nucleic acid or small molecule agents for discovery research and/or therapeutic development, (ii) structural biology and biophysics of macromolecules, complexes and biomolecular condensates, (iii) characterization of DNA, RNA, protein and metabolic interaction networks, (iv) molecular basis of host-microbiome and host-pathogen interactions, and (v) machine learning-driven integration of largescale experimental datasets to generate foundational models. This position will align with the recent SickKids Precision Child Health strategic initiative.
Research themes
Cutting-edge research in molecular medicine
We focus on understanding the relationships between the molecular structures and biological functions of proteins and other macromolecules.
After we get a solid grasp of the molecular basis of both normal biological processes and how they are altered or impaired in human disease, we apply our learnings to develop new strategies for the diagnosis, prevention and treatment of paediatric disease. Our research continues to be the key link between genetic information and the consequences of these genetics at the cell-, tissue-, organ- and organism-levels.

Molecular mechanisms of health and disease
Given the complexity of most diseases, multiple biochemical, cell-based and animal-based studies are required to gain a solid understanding of their mechanisms.
We use a variety of model systems to determine how individual molecules interact, and the signaling and metabolic pathways that are affected in diseases such as diabetes, cancer, neurological, genetic and metabolic diseases, as well as in infectious disease and those that interact closely with the microbiome. Proteins are the primary focus, but small metabolites/drugs, lipids, nucleic acids and sugars are also studied.

Drug discovery, targeted diagnostics and therapeutics
New therapeutics are needed for many diseases such as cystic fibrosis, heart failure, HIV/AIDS, infectious and parasitic diseases – especially with the emergence of strains resistant to current drugs such as COVID-19. Members of the program are involved in drug discovery, using high-throughput and functional screens to identify undiscovered therapeutic compounds and understanding their modes of action.

-
Featured speaker: Dr. Robert Ryan from the University of Nevada
Molecular Medicine Special Seminar: Dr. Robert Ryan
Oct 10, 2025, 10:00 a.m. to 11:00 a.m., 2nd floor PGCRL (Room 2a/2b) or Zoom
Current Projects
What we're working on today
We're conducting trailblazing molecular research in over 20 SickKids labs and programs. See how we're impacting child health by expanding the sections below.
The Adeli Lab is focused on understanding physiological and pathological mechanisms within the complex gut-brain-liver network that underlie healthy responses to dietary fat and clinical disorders such as obesity, insulin resistance, and type 2 diabetes.
The Adeli Lab's clinical and translational research involves studies of healthy children and adolescents to establish a comprehensive database of reference standards for laboratory biomarkers (blood tests) used to diagnose and monitor medical concerns in paediatrics. Thousands of children have already participated, leading to an online database available to healthcare professionals in children's hospitals in Canada and around the world.
Principal Investigator: Dr. Khosrow Adeli
The Bear Lab focuses on understanding the mechanisms that determine variations in lung health amongst individuals. They study this question through the lens of the genetic disease, Cystic Fibrosis (CF), where each affected person can experience disease and respond to therapy differently.
Dr. Christine Bear brings her expertise in studying the function of airways tissues in the lab, to collaborate with experts in stem cell biology, genomics, computational science and clinicians to develop tools to predict the best therapy for each CF patient.
Principal Investigator: Dr. Christine Bear
Dr. Charles Deber’s research program focuses on natural and de novo designed hydrophobic peptides and proteins, using spectroscopic techniques, molecular biology and molecular modeling to increase understanding of how amino acid sequence influences the peptide and protein interactions within membranes, and induces disease states from misfolding of membrane proteins.
Current projects include:
- The development of novel peptide antibiotics
- Design of peptide-based inhibitors of bacterial multidrug resistance
- Studies on the mechanism of action of correctors and potentiators in cystic fibrosis therapy
- Studies aimed at defining the role of hydrophobicity in membrane environments
Principal Investigator: Dr. Charles Deber
The Ditlev Lab aims to understand how liquid-like compartments (similar to the liquid in a lava lamp) in brain and immune cells control cell-cell communication. They're specifically interested in how the molecules within liquid-like compartments work together to cause a cell to act in response to external signals.
Principal Investigator: Dr. Jonathon Ditlev
Standard tools to study proteins, the primary active biological molecules, do not easily apply to the third of sequences that do not fold into ordered structure and are instead intrinsically disordered.
The Forman-Kay Lab develops experimental and computational tools and applies them to disordered proteins involved in critical biological processes. These include disordered proteins that drive phase separation to regulate cellular organization and RNA processing, with links to cancer, autism and other diseases.
Principal Investigator: Dr. Julie Forman-Kay
Dr. Howell’s lab is focused on understanding at the molecular and cellular level biological processes involved in microbial pathogenesis. Her current research is focused on processes that are critical for bacterial and fungal biofilm development, and the development of novel approaches and therapeutics to combat chronic life-threatening microbial infections.
Principal Investigator: Dr. Lynne Howell
Surface glycoproteins on immune cells often play critical roles that directly influence responses to invading pathogens.
The Julien Lab's work enables a better understanding of their atomic structure and the three-dimensional molecular complexes they form, to gain insight into their specific functions. This molecular understanding provides roadmaps for their team to design improved vaccines against pathogens of global health importance, and treatments in cancer and autoimmune diseases.
Principal Investigator: Dr. Jean-Philippe Julien
Professor Kay’s research cuts across the interface of physical chemistry and medical sciences. His work focuses on transforming the techniques of nuclear magnetic resonance (NMR) spectroscopy as applied to the study of large proteins and their complexes, in particular those that are involved in health and disease.
Principal Investigator: Dr. Lewis Kay
The Keeley Lab has a long-standing interest in the biochemistry of elastin, an unusual, rubber-like protein providing properties of extensibility and elastic recoil to large arteries, heart valves and many other tissues. In particular, they study how protein sequence determines assembly and physical properties of polymeric elastin, and how alterations in protein sequence can affect elastic properties, with both physiological and potentially pathological consequences.
Principal Investigator: Dr. Frederick Keeley
The Letarte Lab focuses on leukocyte membrane proteins using monoclonal antibodies, biochemical purification and cloning of corresponding genes, including CALLA, CD44, and endoglin.
Endoglin is mutated in the vascular disorder Hereditary Hemorrhagic Telangiectasia type I (HHT1), enabling their team to develop a molecular diagnosis, identify close to 200 mutations, generate a mouse model of HHT, identify haploinsufficiency as the underlying mechanism of disease and study pathways implicated in the disease.
Dr. Letarte currently organizes graduate courses in Immunology in low-income countries with the Education Committee of the International Union of Immunological Societies.
The Lingwood Lab research focus has been on the biology, function and utility of cellular glycosphingolipids, particularly in microbial pathogenesis and cancer. This led to their promotion of shiga/verotoxin as an antineoplastic and the use of derivatives of such glycolipid binding toxins to ameliorate the pathology of genetic protein misfolding deficiency diseases.
Studies on HIV gave rise to new inhibitors which currently focus on modulators of RNA processing to provide novel pan-viral control.
Principal Investigator: Dr. Clifford Lingwood
Research from the Maynes Lab primarily involves finding new ways to quantify drug action, both therapeutic and toxic, including how to improve the clinical effect of anesthetics and pain medications.
The lab has developed new therapies for heart failure and has created testing platform that measure heart function for the purposes of drug discovery. He collaborates with both academics and industry to bring new therapies into clinical practice.
Principal Investigator: Dr. Jason Maynes
The Melnyk Lab has significant interest in studying the molecular mechanisms that underlie disease pathogenesis, and in applying this information towards the development of new therapeutics.
A large part of their current research focus centers on understanding how bacterial toxins produced by many superbugs enter and damage human cells as a means to develop anti-toxin therapeutics. In addition, through protein engineering, they exploit the remarkable cell-penetrating properties of toxins to deliver protein-based therapeutics into cells.
Principal Investigator: Dr. Roman Melnyk
The Parkinson Lab is focused on the role of microbes in health and disease. Combining genome analyses with sophisticated computational models, Dr. Parkinson and his team are investigating the biochemical pathways by which pathogens and parasites are able to infect and cause disease.
In recent work, these investigations have extended to the role of complex microbial communities (microbiomes) in our bodies and how changes in these communities contribute to chronic diseases such as obesity, malnutrition and inflammatory bowel disease, providing exciting opportunities to develop novel therapeutics to help eliminate infections and promote gut health.
Principal Investigator: Dr. John Parkinson
The Pomès team specializes in the development of computational methods and their application to the study of biological processes. They use computer simulations to gain insight into molecular machines at microscopic scales that are difficult to observe experimentally.
Current applications of their research include tissue elasticity, cystic fibrosis, periodic paralysis, and Alzheimer’s disease.
Principal Investigator: Dr. Régis Pomès
The Roifman translational research program focuses on unravelling the underlying causes of primary immunodeficiency. Using state-of-the-art next generation sequencing technologies as well as molecular and cellular techniques, my team explores the functional impact of novel genetic aberrations on key components of the immune signalling pathways.
As clinician scientists, these discoveries play an important role in guiding precision treatment options.
Principal Investigator: Dr. Chaim Roifman
The Rubinstein Lab develops and utilizes cryo-electron microscopy methods to understand, at an atomic level, how cells convert energy between different forms. They use this knowledge to aid the development of drugs that target these bioenergetic processes to treat diseases ranging from tuberculosis to neurological disorders.
Principal Investigator: Dr. John Rubinstein
The Sarkar Lab focuses on developing rational treatments for Wilson and Menkes diseases - two metal-related genetic diseases. Several heavy metal transporters are investigated to determine the factors responsible for their transport activity in humans.
Studies are carried out to investigate the effects of toxic metals in the global environment and their impact on human health.
Principal Investigator: Dr. Bibudhendra Sarkar
The Sharpe Lab uses structural and biophysical tools to determine the molecular basis for protein self-assembly in biological and disease contexts.
Areas of focus include elucidating how tropoelastin forms the elastic fibres that are essential for cardiovascular and pulmonary function, development of model elastic proteins with potential biomaterials applications, and understanding the mechanisms of lipid-binding and misfolding of the inflammatory response protein serum amyloid A.
Principal Investigator: Dr. Simon Sharpe
Dr. Smith’s primary research interest is the structural chemistry of insulin. His work on the effect that variations in sequence have on hexamer dissociation have important implications in the timing of action of therapeutic insulin preparations used for the control of diabetes.
A secondary interest is the application of Direct Methods in X-ray crystallography to the determination of protein structures.
Principal Investigator: Dr. David Smith
The Youn Lab studies biomolecular condensates that organize subcellular systems and govern their ability to deal with stress. The team uses proteomics, genomics, and cell biological tools to investigate the organization, dynamics, and function of these condensates.
Results provide new strategies to understand and treat neurodegenerative disorders, cancer and infectious diseases.
Principal Investigator: Dr. Ji-Young Youn

March 13, 2025
Newly uncovered mechanism could drive next-gen cystic fibrosis treatments
Protein clustering mechanism on the cell membrane presents a new therapeutic target for cystic fibrosis.

January 28, 2025
Dr. Lewis Kay honoured with Alexander Hollaender Award in Biophysics
The SickKids scientist was honoured for his groundbreaking work in biochemistry and nuclear magnetic resonance (NMR) spectroscopy.

November 19, 2024
SickKids scientists among the most influential in the world in 2024
The researchers are among 206 Canadian scientists on Clarivate’s Highly Cited Researchers 2024 list.

Senior Scientist Emeritus
bsarkar@sickkids.ca

Scientist, Molecular Medicine
brett.trost@sickkids.ca
Director, Canadian Centre for Primary Immunodeficiency, Division of Immunology and Allergy
chaim.roifman@sickkids.ca

Senior Scientist, Molecular Medicine
deber@sickkids.ca

Senior Scientist, Molecular Medicine
bear@sickkids.ca
Scientist Emeritus, Molecular Medicine
cling@sickkids.ca
Senior Scientist Emeritus, Molecular Medicine

Senior Scientist Emeritus, Molecular Medicine
fwk@sickkids.ca

Chief, Department of Anesthesia and Pain Medicine
jason.maynes@sickkids.ca

Senior Scientist, Molecular Medicine
jean-philippe.julien@sickkids.ca

Scientist, Molecular Medicine
jiyoung.youn@sickkids.ca
Senior Scientist Emeritus, Molecular Medicine
jmboggs@sickkids.ca
2019
- American Association for Clinical Chemistry Academy - Outstanding Research Award
2020
- W. H. and W. L. Bragg Prize for outstanding early-career crystallographers
- Young Investigators Award, Amgen
- New Investigator Award – Canadian Society for Immunology
2019
- Member of the College of New Scholars, Artists and Scientists of the Royal Society of Canada – Royal Society of Canada
- Azrieli Global Scholar – Canadian Institute for Advanced Research
2020
- Doctorate of Philosophy honoris causa - Stockholm University
- National Lecturer - Biophysical Society of Canada
Contact Molecular Medicine
Joanne Sitarski, Program Manager
686 Bay St, Toronto, ON M5G 0A4
416-813-5377